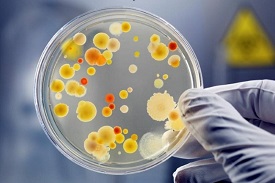

Подкасти
Експерти: Ульріке Моргенштерн
Переклала: Надія Федчишин, професорка, завідувачка кафедри іноземних мов Тернопільського національного медичного університету імені І.Я. Горбачевського МОЗ України
Презентує: Марʼяна Варварук

Експерти: Ульріке Моргенштерн та Ванеса Ратке
Переклала: Надія Федчишин, професорка, завідувачка кафедри іноземних мов Тернопільського національного медичного університету імені І.Я. Горбачевського МОЗ України
Презентує: Марʼяна Варварук

Автори: Ульріке Моргенштерн та Жозефіна Панневіц
Переклала: Надія Федчишин, професорка, завідувачка кафедри іноземних мов Тернопільського національного медичного університету імені І.Я. Горбачевського МОЗ України
Презентують: Марʼяна Варварук та Михайло Бучинський

Авторка – професорка, докторка Моргенштерн (Professor Dr. Morgenstern), Акконський університет гуманітраних наук, Берлін, Німеччина.
Переклала професор Надія Федчишин, завідувач кафедри іноземних мов Тернопільського національного медичного університету імені І.Я. Горбачевського МОЗ України.
Контакти: fedushunno@tdmu.edu.ua.
Презентує Марʼяна Варварук.

Цей випуск створено на основі подкасту про антибіотики InfectEd, створенному Інститутом гігієни та екологічної медицини Шаріте за підтримки Інституту інфекційної медицини та госпітальної гігієни Університетської лікарні Єни та Інституту гігієни та мікробіології Вюрцбурзького університету, а також експертів з практичної інфекційної медицини та студентів інфекційної медицини Шаріте. Експерт – доктор Гартмут Штоккер (Dr. Hartmut Stocker), Головний лікар клініки інфектології лікарні Святого Йосипа в Берліні (Темпельгоф).
Переклала професор Надія Федчишин, завідувач кафедри іноземних мов Тернопільського національного медичного університету імені І.Я. Горбачевського МОЗ України.
Контакти: fedushunno@tdmu.edu.ua.
Презентують Оксана Лабівка та Михайло Бучинський.

Цей випуск створено на основі подкасту про антибіотики InfectEd, створенному Інститутом гігієни та екологічної медицини Шаріте за підтримки Інституту інфекційної медицини та госпітальної гігієни Університетської лікарні Єни та Інституту гігієни та мікробіології Вюрцбурзького університету, а також експертів з практичної інфекційної медицини та студентів інфекційної медицини Шаріте.
Експерт – доктор Маттіас Грюндлінг (PD Dr. Matthias Gründling), керівник групи дослідження клінічного сепсису, Університетська медицина Грайфсвальда, Грайфсвальд.
Переклала професор Надія Федчишин, завідувач кафедри іноземних мов Тернопільського національного медичного університету імені І.Я. Горбачевського МОЗ України.
Контакти: fedushunno@tdmu.edu.ua.
Презентують Марʼяна Варварук та Оксана Лабівка.

Цей випуск створено на основі подкасту про антибіотики InfectEd, створенному Інститутом гігієни та екологічної медицини Шаріте за підтримки Інституту інфекційної медицини та госпітальної гігієни Університетської лікарні Єни та Інституту гігієни та мікробіології Вюрцбурзького університету, а також експертів з практичної інфекційної медицини та студентів інфекційної медицини Шаріте. Експертка – доктор Кароліна Існер (Dr. med. Caroline Isner), головна лікарка клініки внутрішньої медицини – інфектології, керівниця відділу управління антибіотиками Центру інфекційної медицини Auguste-Viktoria-Klinikum
Переклала професор Надія Федчишин, завідувач кафедри іноземних мов Тернопільського національного медичного університету імені І.Я. Горбачевського МОЗ України.
Контакти: fedushunno@tdmu.edu.ua.
Презентують Марʼяна Варварук та Оксана Лабівка.

Експерти – професор Кай О. Хенсель (Prof. Dr. med. Kai O. Hensel), доктор медичних наук, директор Центру дитячої та підліткової медицини, спеціаліст з педіатрії, додаткова кваліфікація з дитячої гастроентерології, сертифікація з гастроентерології GPGE, спеціалізація з неонатології, кваліфікація з неонатальної медицини невідкладних станів (GNPI), додаткова кваліфікація з медицини невідкладних станів, програма PhD з біомедицини, творець і ведучий педіатричного подкасту “Die Expertise-Piraten” та доктор Міхаель Зассе (Dr. med. Michael Sasse), спеціаліст в галузі дитячої та підліткової терапії, фахівець з дитячої реаніматології та лікар невідкладної медичної допомоги. Понад 20 років очолював педіатричне відділення інтенсивної терапії в університетській лікарні в Ганновері, очолює мережу дитячої інтенсивної терапії на півночі Німеччини та співпрацює з Німецькою радою реанімації.
Переклала професор Надія Федчишин, завідувач кафедри іноземних мов Тернопільського національного медичного університету імені І.Я. Горбачевського МОЗ України.
Контакти: fedushunno@tdmu.edu.ua.
Презентують Анна Черноус та Михайло Бучинський.

Експерти – доктор Аксель Еннінгер (Dr. Axel Enninger), медичний директор відділення загальної та спеціальної педіатрії клініки Штутгарта, професорка Маргітта Ворм (Prof. Dr. med. Margitta Worm), спеціаліст з дерматології та венерології, має додаткову спеціалізацію з алергології, медицини навколишнього середовища та дієтології, очолює університетську амбулаторію та координує викладання дерматології, венерології та алергології в клініці Шаріте в Берліні та доктор Ларс Ланге (Dr. Lars Lange), дитячий алерголог і головний лікар у дитячій клініці лікарні Марієн у Бонні.
Переклала професор Надія Федчишин, завідувач кафедри іноземних мов Тернопільського національного медичного університету імені І.Я. Горбачевського МОЗ України.
Контакти: fedushunno@tdmu.edu.ua.
Презентують Марʼяна Варварук, Анна Черноус та Михайло Бучинський.
Цей випуск створено на основі подкасту від Consilium Pediatrics.

Цей випуск створено на основі подкасту про антибіотики InfectEd, створенному Інститутом гігієни та екологічної медицини Шаріте за підтримки Інституту інфекційної медицини та госпітальної гігієни Університетської лікарні Єни та Інституту гігієни та мікробіології Вюрцбурзького університету, а також експертів з практичної інфекційної медицини та студентів інфекційної медицини Шаріте.
Експерти – доктор Ральф Отто-Кнапп (Dr. Ralf Otto-Knapp) та доктор Бріт Гаккер (Dr. Brit Hacker), співробітники Німецького центрального комітету боротьби з туберкульозом.
Переклала професор Надія Федчишин, завідувач кафедри іноземних мов Тернопільського національного медичного університету імені І.Я. Горбачевського МОЗ України.
Контакти: fedushunno@tdmu.edu.ua.
Презентують Анна Черноус та Михайло Бучинський.

Експерти – доктор Аксель Еннінгер (Dr. Axel Enninger), медичний директор відділення загальної та спеціальної педіатрії клініки Штутгарта і доктор Мартин Лаас (Dr. Martin Laaß), головний лікар Університетської дитячої лікарні в Дрездені, дитячий гастроентеролог.
Переклала професор Надія Федчишин, завідувач кафедри іноземних мов Тернопільського національного медичного університету імені І.Я. Горбачевського МОЗ України.
Контакти: fedushunno@tdmu.edu.ua.
Презентують Анна Черноус та Михайло Бучинський. Цей випуск створено на основі подкасту від Consilium Pediatrics.

Експерти – доктор Аксель Еннінгер (Dr. Axel Enninger), медичний директор відділення загальної та спеціальної педіатрії клініки Штутгарта і доктор Даніель Вільсер (Dr. Daniel Vilser), з Університетської дитячої лікарні в місті Єна.
Переклала професор Надія Федчишин, завідувач кафедри іноземних мов Тернопільського національного медичного університету імені І.Я. Горбачевського МОЗ України.
Контакти: fedushunno@tdmu.edu.ua.
Презентують Марʼяна Варварук та Орест Степанюк. Цей випуск створено на основі подкасту від Consilium Pediatrics.

Експерти – доктор Аксель Еннінгер (Dr. Axel Enninger), медичний директор відділення загальної та спеціальної педіатрії клініки Штутгарта і професор Ульріх Гайнінгер (Prof. Dr. med. Ulrich Heininger), головний лікар відділення дитячих інфекційних захворювань та вакцинології Університетської дитячої лікарні в місті Базель.
Переклала професор Надія Федчишин, завідувач кафедри іноземних мов Тернопільського національного медичного університету імені І.Я. Горбачевського МОЗ України.
Контакти: fedushunno@tdmu.edu.ua.
Презентують Анна Черноус та Михайло Бучинський.

Експерти – доктор Аксель Еннінгер (Dr. Axel Enninger), медичний директор відділення загальної та спеціальної педіатрії клініки Штутгарта і доктор Мартін Классен (Dr. Martin Claßen), колишній керівник клініки педіатрії та підліткової медицини в Клініці Лікс-дер-Весер та педіатричної клініки в Клініці Бремен Мітте, дитячий та підлітковий гастроентеролог з 40-річним досвідом.
Переклала професор Надія Федчишин, завідувач кафедри іноземних мов Тернопільського національного медичного університету імені І.Я. Горбачевського МОЗ України.
Контакти: fedushunno@tdmu.edu.ua.
Презентують Мар’яна Варварук та Михайло Бучинський.

Цей випуск створено на основі подкасту інфекційної клініки Consilium infectiorum. Експерт – професор Матіас Плетц (Prof. Dr. med. Mathias Pletz), директор Інституту інфекційних захворювань та лікарняної гігієни лікарні Йенського університету.
Переклала професор Надія Федчишин, завідувач кафедри іноземних мов Тернопільського національного медичного університету імені І.Я. Горбачевського МОЗ України.
Контакти: fedushunno@tdmu.edu.ua.
Презентують Мар’яна Варварук та Михайло Бучинський.
Відмова від відповідальності: уся клінічна інформація в подкасті надається відповідно до наших знань і переконань.
Однак вони ніколи не можуть замінити індивідуальну оцінку кожного пацієнта та індивідуальне рішення про терапію, прийняте досвідченим клініцистом на місці.

Цей випуск створено на основі подкасту інфекційної клініки Consilium infectiorum. В оригіналі професор Матіас Плетц (Prof. Dr. med. Mathias Pletz), директор Інституту інфекційних захворювань та лікарняної гігієни лікарні Йенського університету бере інтерв’ю у професора Крістіана Екманна (Prof. Dr. med. Christian Eckmann), головного лікаря загальної, вісцеральної та торакальної хірургії Клініки Ганноверш Мюнден.
Переклала професор Надія Федчишин, завідувач кафедри іноземних мов Тернопільського національного медичного університету імені І.Я. Горбачевського МОЗ України.
Контакти: fedushunno@tdmu.edu.ua.
Презентують Мар’яна Варварук та Михайло Бучинський.
Відмова від відповідальності: уся клінічна інформація в подкасті надається відповідно до наших знань і переконань.
Однак вони ніколи не можуть замінити індивідуальну оцінку кожного пацієнта та індивідуальне рішення про терапію, прийняте досвідченим клініцистом на місці.

Цей випуск створено на основі подкасту інфекційної клініки Consilium infectiorum. В оригіналі професор Матіас Плетц (Prof. Dr. med. Mathias Pletz), директор Інституту інфекційних захворювань та лікарняної гігієни лікарні Йенського університету бере інтерв’ю у професорки Норми Юнг (Prof. Dr. Norma Jung), старшої лікарки, завідувачки відділення з призначення антибіотиків в Університетській клініці Кельна.
Переклала професор Надія Федчишин, завідувач кафедри іноземних мов Тернопільського національного медичного університету імені І.Я. Горбачевського МОЗ України.
Контакти: fedushunno@tdmu.edu.ua.
Презентують Мар’яна Варварук та Михайло Бучинський.
Відмова від відповідальності: уся клінічна інформація в подкасті надається відповідно до наших знань і переконань.
Однак вони ніколи не можуть замінити індивідуальну оцінку кожного пацієнта та індивідуальне рішення про терапію, прийняте досвідченим клініцистом на місці.

Цей випуск створено на основі подкасту про антибіотики InfectEd, створенному Інститутом гігієни та екологічної медицини Шаріте за підтримки Інституту інфекційної медицини та госпітальної гігієни Університетської лікарні Єни та Інституту гігієни та мікробіології Вюрцбурзького університету, а також експертів з практичної інфекційної медицини та студентів інфекційної медицини Шаріте.
Переклала професор Надія Федчишин, завідувач кафедри іноземних мов Тернопільського національного медичного університету імені І.Я. Горбачевського МОЗ України.
Контакти: fedushunno@tdmu.edu.ua.
Презентують Мар’яна Варварук та Михайло Бучинський.

Експерт – доктор Енріко Кюнле (Dr. Enrico Kühnle), старший лікар з ранньої неврологічної реабілітації в клініці VAMED в Хаттінгені
Переклала професор Надія Федчишин, завідувач кафедри іноземних мов Тернопільського національного медичного університету імені І.Я. Горбачевського МОЗ України.
Контакти: fedushunno@tdmu.edu.ua.
Презентують Михайло Бучинський та Мар’яна Варварук.

Експерти – професор Тілль Газенберг (Professor Till Hasenberg) та доктор медицини Петер Кауп (Dr. Peter Kaub), член команди I.S.A.R. (Німеччина)
Переклала професор Надія Федчишин, завідувач кафедри іноземних мов Тернопільського національного медичного університету імені І.Я. Горбачевського МОЗ України.
Контакти: fedushunno@tdmu.edu.ua.
Презентують Михайло Бучинський та Мар’яна Варварук.

Експерт – професор, доктор Маріса Пширембель (Prof. Dr. Marisa Przyrembel), Акконський університет гуманітарних наук, Берлін, Німеччина
Контакти для листування: marisa.przyrembel@akkon-hochschule.de, телефон: +49-30-809 2332-373
Переклад – Тетяна Хвалибога, доктор педагогічних наук, доцент кафедри іноземних мов Тернопільського національного медичного університету імені І. Я. Горбачевського
Презентує – Марʼяна Варварук

Експерт – доктор Біргіт Кірш (Dr. Birgit Kirsch), старша лікарка Клініці судинної хірургії, Німеччина.
Переклала професор Надія Федчишин, завідувач кафедри іноземних мов Тернопільського національного медичного університету імені І.Я. Горбачевського МОЗ України.
Контакти: fedushunno@tdmu.edu.ua.
Презентує Мар’яна Варварук.
Відмова від відповідальності:
Ми пропонуємо в подкасті всю клінічну інформацію щодо запропонованої теми.
Ми не намагалися змінити оцінку кожного конкретного випадку щодо певного пацієнта, чи окреме заключення про терапію, які прийняті досвідченими клініцистами на місці події. Тут мова піде про визначення, класифікацію ступеня тяжкості, діагностику та терапію.

Цей випуск створено на основі подкасту про антибіотики InfectEd, створенному Інститутом гігієни та екологічної медицини Шаріте за підтримки Інституту інфекційної медицини та госпітальної гігієни Університетської лікарні Єни та Інституту гігієни та мікробіології Вюрцбурзького університету, а також експертів з практичної інфекційної медицини та студентів інфекційної медицини Шаріте.
В кожному епізоді студенти-медики та лікар ставлять питання експерту на інфекційну тему. Тут ми підготували узагальнену версію цього діалогу та його переклад.
Посилання на оригінал німецькомовного подкасту
Переклала професор Надія Федчишин, завідувач кафедри іноземних мов Тернопільського національного медичного університету імені І.Я. Горбачевського МОЗ України.
Контакти: fedushunno@tdmu.edu.ua.
Презентують Мар’яна Варварук та Михайло Бучинський
Авторка – Інес Хайнц (Ines Heinz), Німецький фонд боротьби з депресією, Лейпциг, Німеччина, контактная інформація – ines.heinz@deutsche-depressionshilfe.de
Переклад – Ольга Костіна
Презентує Мар”яна Варварук
Інформація про депресію для пацієнтів, їхніх родин і друзів, а також для медичних працівників надається за адресою: https://ifightdepression.com/en/

Цей випуск стосується особливого навантаження в системі охорони здоров’я: коли працівники лікарень, медичних установ, служб екстреної допомоги стикаються з травматичними ситуаціями, або мають справу з пацієнтами, які пережили травматичні події.
Крім знань про основи того, як виникають стрес і травматичні навантаження, ви зможете отримати корисні поради і підказки щодо надання першої психологічної допомоги. Тут ми обговоримо роботу з моральними травмами та їх психологічні наслідки. Коротко про найголовніше експерти Берлінського центру психотравми Бундесверу (Німеччина).
Переклала професор Надія Федчишин, завідувач кафедри іноземних мов Тернопільського національного медичного університету імені І.Я. Горбачевського МОЗ України.
Контакти: fedushunno@tdmu.edu.ua
Презентує Мар”яна Варварук.
Відмова від відповідальності: вся клінічна інформація в подкасті надана з урахуванням наших знань і переконань. Однак вона ніколи не може замінити індивідуальну оцінку кожного пацієнта та індивідуальне терапевтичне рішення, прийняте досвідченим лікарем на місці.

Видавець: Німецьке товариство загальної та сімейної медицини
Автори: Фредерік Мадер (Frederik M. Mader) і РетоШвенке (Reto Schwenke)
Переклала професор Надія Федчишин, завідувач кафедри іноземних мов Тернопільського національного медичного університету імені І.Я. Горбачевського МОЗ України.
Контакти: fedushunno@tdmu.edu.ua.
Презентує Марʼяна Варварук.

Автор: Моніка Ленц (Monika Lenz,), спеціаліст із загальної медицини, Нойштадт-ам-Рюбенберге (Німеччина).
Видавець: Deximed – GesinformGmbH, Moltkestraße 13, 79098 Freiburg, info@gesinform.de
Посилання: https://deximed.de/home/klinische-themen/physiotherapie-sportmedizin/prüfungen-interventionen/interventionen/amputationen
Переклала професор Надія Федчишин, завідувач кафедри іноземних мов Тернопільського національного медичного університету імені І.Я. Горбачевського МОЗ України.
Контакти: fedushunno@tdmu.edu.ua.
Презентує Марʼяна Варварук.
Подкаст підготовлено на основі наступних даних:
1. Німецького товариства ортопедії та ортопедичної хірургії з теми “Реабілітація після ампутації нижньої кінцівки (аж до стопи). Рекомендації AWMF № 033-044. S2k, станом на 2019 р.”
2. Німецького товариства ангіології – Товариства судинної медицини з теми «Оклюзійне захворювання периферичних артерій: діагностика, терапія та догляд. Рекомендації AWMF № 065-003. S3, станом на 2015 р. Програма NVL від BÄK, KBV, AWMF.
3. Національних рекомендацій в області охорони здоров’я (NVL): щодо профілактики діабету 2 типу та стратегії лікування ускладнень стопи, станом на 2006 р. (переглядається).
4. Німецького товариства загальної та сімейної медицини (DEGAM) з теми «Хронічний біль, алгоритм S1. Рекомендації AWMF № 053-036. S1, станом на 2013 рік (на стадії перегляду).
5. Німецького товариства лікування болю з теми «Довгострокове використання опіоїдів для лікування неонкологічного болю (LONTS). Рекомендації AWMF № 145-003. S3, станом на 2020 р.

Продовження бесіди на тему “Від кабінету сімейного лікаря до відділення інтенсивної терапії – негоспітальна пневмонія”.
Експерт: професор Матіас Плетц, директор Інституту інфекційної медицини та госпітальної гігієни університетської клініки Єнського університету (Німеччина), лікар-терапевт, пневмонолог, інфекціоніст і лікар-гігієніст.
Переклала професор Надія Федчишин, завідувач кафедри іноземних мов Тернопільського національного медичного університету імені І.Я. Горбачевського МОЗ України.
Контакти: fedushunno@tdmu.edu.ua
Презентує Марʼяна Варварук та Михайло Бучинський

Експерт: професор Матіас Плетц, директор Інституту інфекційної медицини та госпітальної гігієни університетської клініки Єнського університету (Німеччина), лікар-терапевт, пневмонолог, інфекціоніст і лікар-гігієніст.
Переклала професор Надія Федчишин, завідувач кафедри іноземних мов Тернопільського національного медичного університету імені І.Я. Горбачевського МОЗ України.
Контакти: fedushunno@tdmu.edu.ua
Презентує Марʼяна Варварук та Михайло Бучинський

Продовження розмови на тему стресу та професійного вигорання в системі охорони здоровʼя від експертів Берлінського центру психотравми Бундесверу (Німеччина).
Переклала професор Надія Федчишин, завідувач кафедри іноземних мов Тернопільського національного медичного університету імені І.Я. Горбачевського МОЗ України.
Контакти: fedushunno@tdmu.edu.ua
Презентує Мар”яна Варварук.
Відмова від відповідальності: вся клінічна інформація в подкасті надана з урахуванням наших знань і переконань. Однак вона ніколи не може замінити індивідуальну оцінку кожного пацієнта та індивідуальне терапевтичне рішення, прийняте досвідченим лікарем на місці.

- Визначення та патогенез ХОЗЛ
- Діагностика ХОЗЛ
- Чи призначати антибіотики при ХОЗЛ?
- Супутні захворювання чи фактори ризику
- Ризики від прийому лікарських препаратів
- Лікування загострення у пацієнта з ХОЗЛ у відділенні інтенсивної терапії
Експерт: професор, доктор Торстен Бауер (Prof. Dr. Torsten Bauer), головний лікар клініки пульманології Heckeshorn (Гекесгорн) у Берліні, президент Німецького товариства пульманології та респіраторної медицини.
Переклала професор Надія Федчишин, завідувач кафедри іноземних мов Тернопільського національного медичного університету імені І.Я. Горбачевського МОЗ України.
Контакти: fedushunno@tdmu.edu.ua
Презентують Мар”яна Варварук та Михайло Бучинський.

Експерт: Ян Дрегер, головний лікар психіатричної клініки в Крефельді, Німеччина.
Переклала професор Надія Федчишин, завідувач кафедри іноземних мов Тернопільського національного медичного університету імені І.Я. Горбачевського МОЗ України.
Контакти: fedushunno@tdmu.edu.ua
Презентує Мар`яна Варварук та Михайло Бучинський.
Цей випуск скорочений перекладений епізод німецького подкасту “Клінічно релевантний. Твій партнер у галузі охорони здоров`я”, який надає фахову інформацію з клінічної практики. Тут ми підготували узагальнену версію цього діалогу та його переклад. Додаткову інформацію та пропозиції можна знайти на веб-сайті klinisch-relevant.de. Ми запропонували для вас цей подкаст відповідно до знань, досвіду та практичної роботи наших експертів. Ми не несемо жодної відповідальності за будь-які помилкові висновки чи проблемні питання, які виникають у зв’язку з представленим тут змістом.

Переклала професор Надія Федчишин, завідувач кафедри іноземних мов Тернопільського національного медичного університету імені І.Я. Горбачевського МОЗ України. Контакти: fedushunno@tdmu.edu.ua
Презентує Марʼяна Варварук

Що таке вигорання і які можливі причини?
Як може розвинутися синдром професійного вигорання?
Чи всі люди однаково піддаються ризикам?
Відмова від відповідальності: вся клінічна інформація в подкасті надана з урахуванням наших знань і переконань. Однак вона ніколи не може замінити індивідуальну оцінку кожного пацієнта та індивідуальне терапевтичне рішення, прийняте досвідченим лікарем на місці.

Контакти: anne-lena.luetzler@
Переклала професор Надія Федчишин, завідувач кафедри іноземних мов Тернопільського національного медичного університету імені І.Я. Горбачевського МОЗ України. Контакти: fedushunno@tdmu.edu.ua
Презентує Мар”яна Варварук.

На основі наступної літератури:
1. Лікування політравми/тяжких травм. Німецьке товариство травматологічної хірургії. (Постанова AWMF № 187-023. S3, станом на 2022 р.)
2. Діагностика та лікування спонтанного пневмотораксу та післяопераційного пневмотораксу. Німецьке товариство торакальної хірургії. (Постанова AWMF № 010-007. S3, станом на 2018 р.) www.awmf.org

Автор: Ліно Вітте, доктор медичних наук, викладач загальної медицини на курсах підвищення кваліфікації, Мюнстер, Німеччина
Видавець: Deximed – Gesinform GmbH, Moltkestraße 13, 79098 Freiburg, info@gesinform.de
Переклала професор Надія Федчишин, завідувач кафедри іноземних мов Тернопільського національного медичного університету імені І.Я. Горбачевського МОЗ України. Контакти: fedushunno@tdmu.
Презентує Мар”яна Варварук.

Переклала професор Надія Федчишин, завідувач кафедри іноземних мов Тернопільського національного медичного університету імені І.Я. Горбачевського МОЗ України.
Презентує: Мар’яна Варварук.

Переклала професор Надія Федчишин, завідувач кафедри іноземних мов Тернопільського національного медичного університету імені І.Я. Горбачевського МОЗ України.
Презентують Михайло Бучинський та Мар”яна Варварук.
Цей випуск перекладений епізод №302 німецького подкасту “Клінічно релевантний. Твій партнер у галузі охорони здоровїя”, який виходить двічі на тиждень – у вівторок та в суботу, і надає фахову інформацію з клінічної практики. Тут ми підготували узагальнену версію цього діалогу та його переклад. Додаткову інформацію та пропозиції можна знайти на веб-сайті klinisch-relevant.de.




Автори: Саскія Ешенбахер, Маріса Пширембель, Акконського університету гуманітарних наук, Берлін, Німеччина.
Переклала та презентує: кандидат медичних наук Ольга Люта, асистент кафедри психіатрії, наркології та медичної психології Тернопільського національного медичного університету імені І.Я. Горбачевського МОЗ України
Контакти: kostinaoo@tdmu.edu.

Автори: Денні Пауліке, Андреас Шенфельд, Акконський університет гуманітарних наук
Контакти: denny.paulicke@akkon-hochschule.de
Переклала та презентує Олена Лотоцька, професор кафедри загальної гігієни та екології Тернопільського національного медичного університету імені І.Я. Горбачевського МОЗ України
Контакти: lototska@tdmu.edu.ua

Автори: Андреас Шенфельд, Денні Пауліке, Акконський університет гуманітарних наук
Контакти: andreas.schoenfeld@akkon-hochschule.de
Переклала та презентує професор Олена Венгер, завідувач кафедри психіатрії, наркології та медичної психології Тернопільського національного медичного університету імені І.Я. Горбачевського МОЗ України
Контакти: venger_ol@tdmu.edu.ua

Автор: Давід Ссекессі, клініка Вест-Бранденбург у Потсдамі (Німеччина)
Контакти: international@klinikumevb.de
Переклала та презентує професор Надія Федчишин, завідувач кафедри іноземних мов Тернопільського національного медичного університету імені І.Я. Горбачевського МОЗ України.
Контакти: fedushunno@tdmu.edu.ua

Автор: Томас Ерлер, клініка ім. Ернста фон Бергмана у Потсдамі
Контакти: international@klinikumevb.de
Переклала та презентує професор Надія Федчишин, завідувач кафедри іноземних мов Тернопільського національного медичного університету імені І.Я. Горбачевського МОЗ України.
Контакти: fedushunno@tdmu.edu.ua.

Автор: Timo Ulrichs, Інститут досліджень міжнародної допомоги Акконського університету гуманітарних наук
Контакти: timo.ulrichs@akkon-hochschule.de
Переклав та презентує Леонід Грищук, професор кафедри пропедевтики внутрішньої медицини та фтизіатрії Тернопільського національного медичного університету імені І.Я. Горбачевського МОЗ України
Контакти: gryshchuk@tdmu.edu.ua

Автор: Ульріке Моргенштерн, Акконський університет гуманітарних наук
Контакти: ulrike.morgenstern@akkon-hochschule.de
Переклала та презентує професор Надія Федчишин, завідувач кафедри іноземних мов Тернопільського національного медичного університету імені І.Я. Горбачевського МОЗ України
Контакти: fedushunno@tdmu.edu.ua

Автор: Кордула Ліпінскі, професійна медична сестра відділення анестезії та інтенсивної терапії, клініка Арнсберг, Менден, Німеччина
Переклала та презентує професор Надія Федчишин, завідувач кафедри іноземних мов Тернопільського національного медичного університету імені І.Я. Горбачевського МОЗ України
Контакти: fedushunno@tdmu.edu.ua


